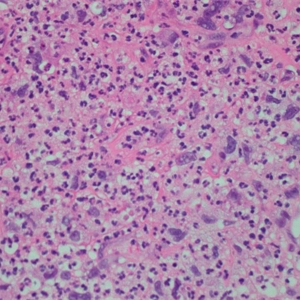
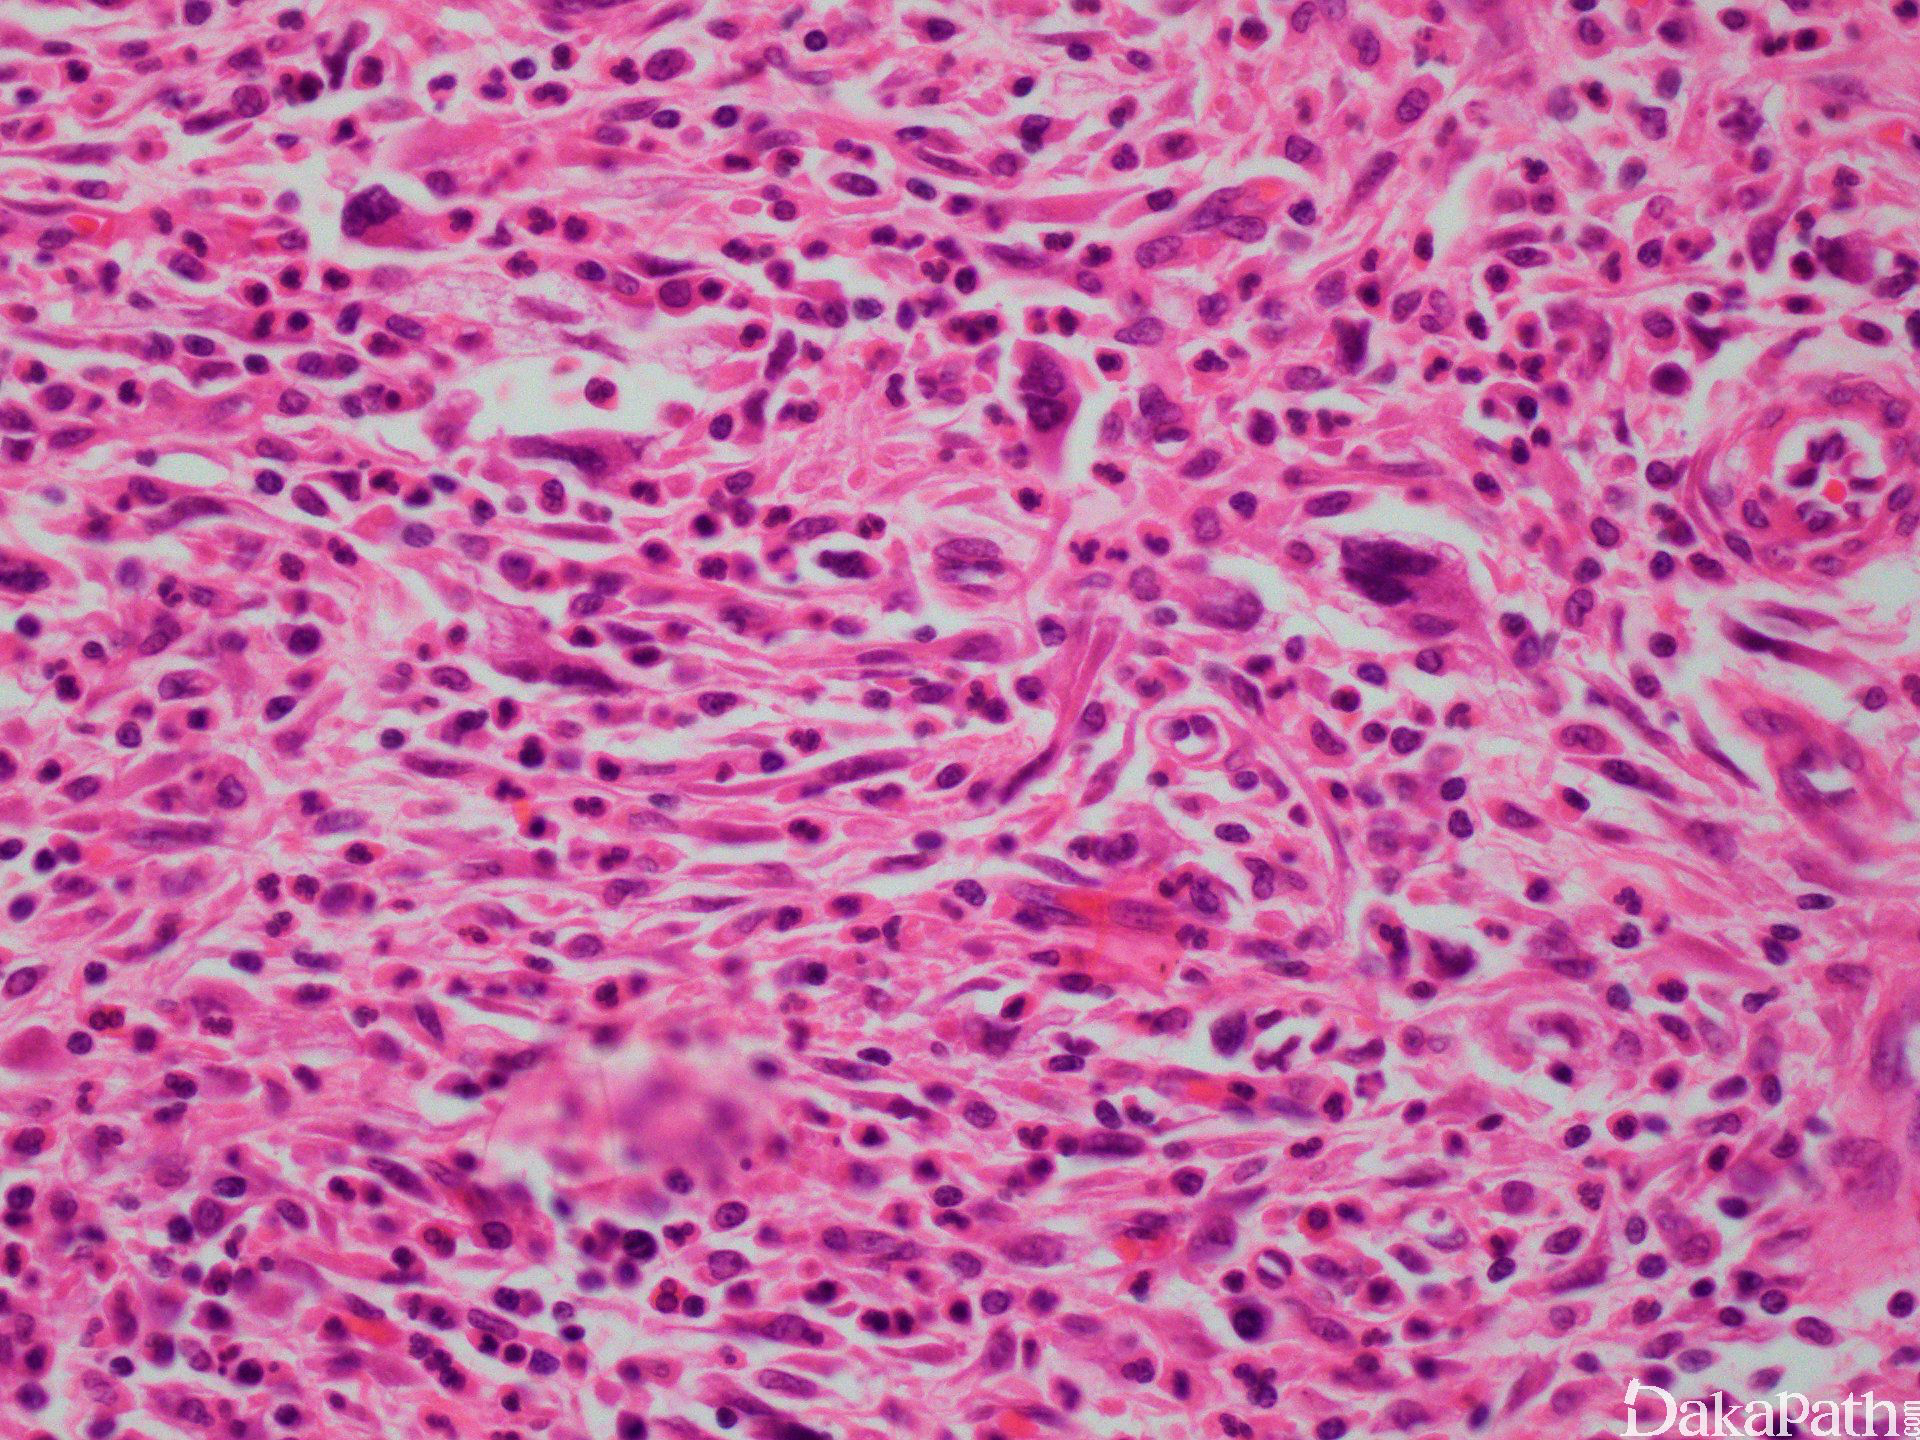
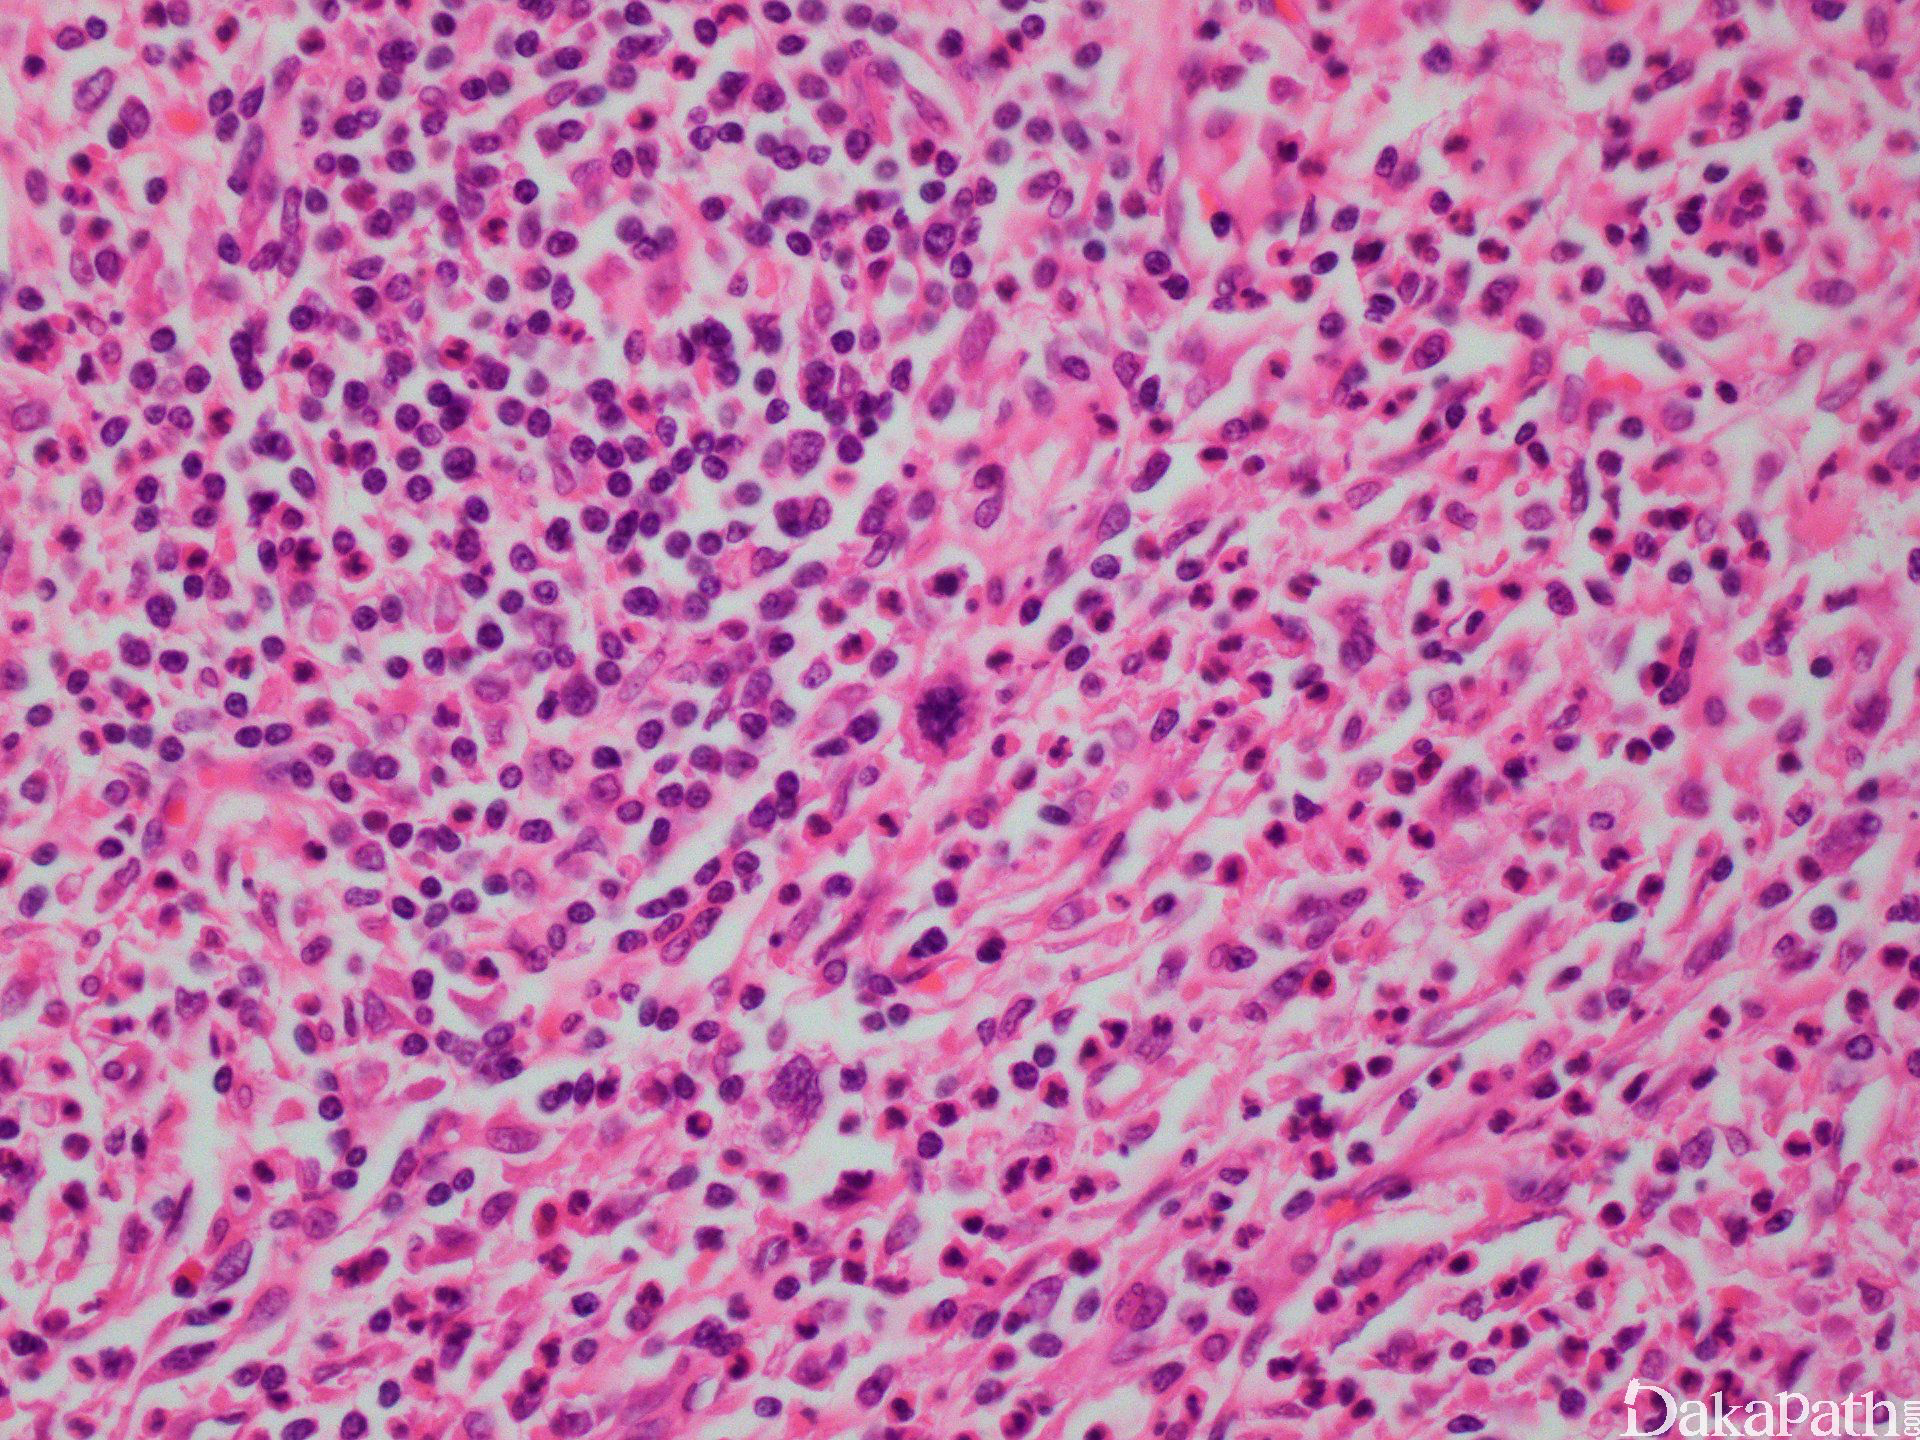
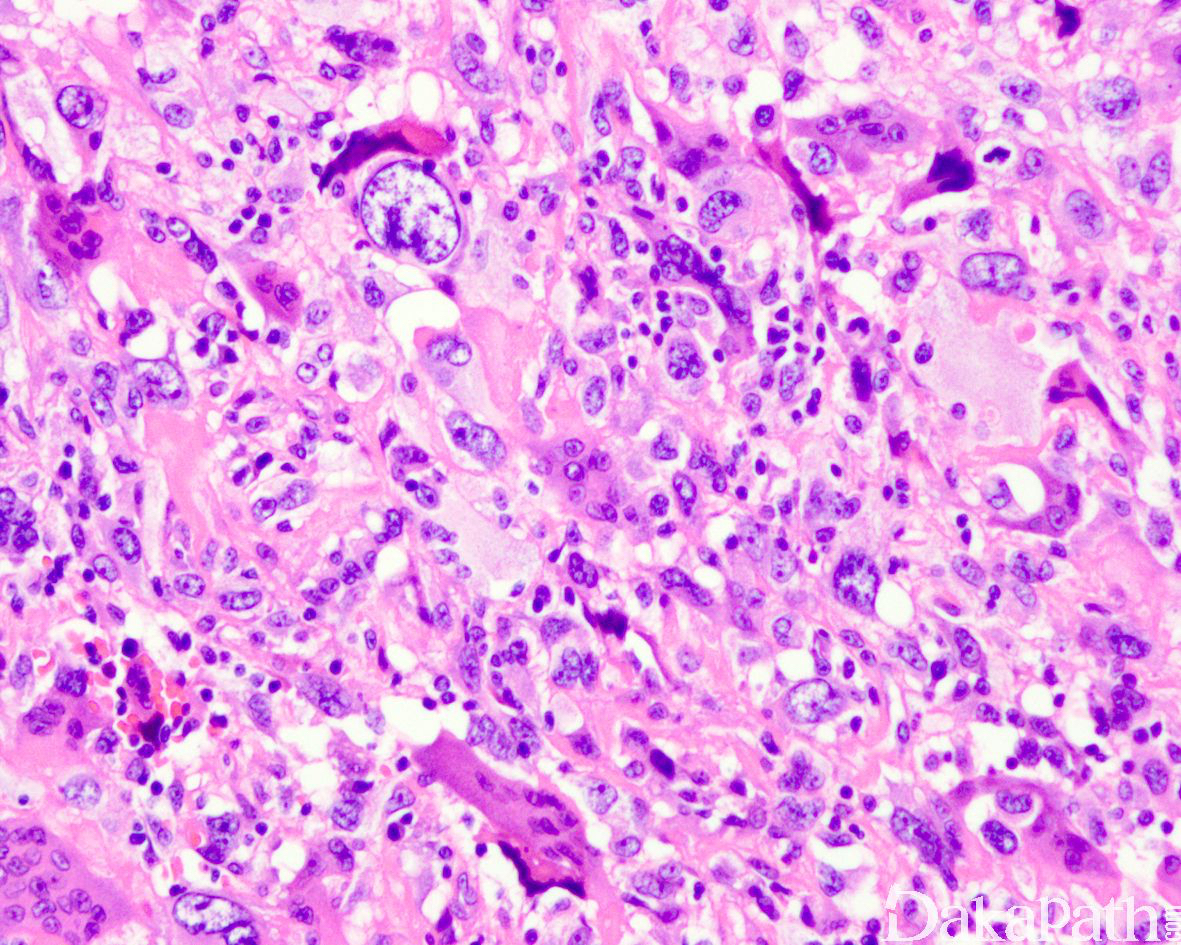

未分化多形性肉瘤
Undifferentiated Pleomorphic Sarcoma
同义词(或曾用名): 恶性纤维组织细胞瘤,Malignant Fibrous Histiocytoma(MFH)
概述:
形态学与其他特殊类型的多形性肉瘤很相似,无一定的排列方式,常伴奇异的多核瘤巨细胞。
发病部位: 老年人最常见的恶性软组织肿瘤,好发于四肢近端和腹膜后,常表现为不断增大的无痛性肿块;
诊断要点:
老年人最常见的恶性软组织肿瘤,好发于四肢近端和腹膜后,常表现为不断增大的无痛性肿块;
大体检查呈孤立性、多分叶状、鱼肉样棕白至灰色的肿块,常见出血和坏死区域;
镜下细胞丰富,可见席纹状结构;
特点为大的多形性细胞,伴有大而深染的细胞核和明显的核仁;
大量核分裂象,常见非典型性核分裂象;
可见玻璃样变和坏死区域,也常见黄色瘤细胞;
各种亚型如下:
黏液样 MFH:
(1)肿瘤 50%以上由黏液样区域组成;
(2)黏液样区域与普通型 MFH 共同组成;
(3)明显的血管结构;
(4)可见大量黄瘤细胞;
炎性 MFH:表现为致密的急性和慢性炎性细胞浸润;
多形性 MFH:
(1)显现奇异的肿瘤巨细胞;
(2)大量核分裂象,包括非典型核分裂象;
- 巨细胞性 MFH:
(1)普通型 MFH 区域出现破骨细胞样巨细胞,肿瘤常呈多结节状生长,常见出血、坏死和囊性变;
(2)必须与骨巨细胞瘤扩散至骨外相鉴别:破骨样巨细胞成分相似,然而巨细胞性 MFH 的背景肿瘤细胞细胞表现为恶明显的异型性;
特殊染色和免疫组织化学:vimentin、CD68 阳性;
预后:
侵袭性肿瘤,伴有复发倾向;
远处转移常见于肺,其次为骨和肝;
深度和部位是重要的预后因素;
治疗以扩大切除为主;
MFH 可能与既往放射线照射有关。

免疫组织化学染色:
无特征性标记,vimentin、CD68 阳性;actins、结蛋白和 h-caldesmon 可局灶阳性,偶可表达 CK 和 EMA,少数病例还可局灶表达 S-100,不表达 HMB45,常见 P53 过表达和 Rb1 蛋白表达缺失,其诊断往往是排除性诊断。
鉴别诊断:
黏液性脂肪肉瘤 :
由空泡状脂母细胞组织,间质黏液样;
常见纤细的丛状毛细血管结构;
S-100(+);
多形性脂肪肉瘤:以奇异的巨大脂母细胞为特征,S-100(+);
多形性横纹肌肉瘤 :大的多形性横纹肌母细胞,可能见到胞质横纹,DES、MyoD1(+);
平滑肌肉瘤 :一般能见到经典的平滑肌肉瘤区域,瘤细胞至少表达一种象征平滑肌分化的抗原,如 α-SMA、MSA、结蛋白、h-caldesmon 和 calponin。
恶性黑色素瘤 :瘤细胞除表达 S-1 00 外,还可表达 HMB45 和 A103. SOX10. CD117 等;
去分化脂肪肉瘤:与多形性未分化肉瘤存在明显的重叠,在后腹膜等部位的多形性未分化肉瘤样肿瘤需要仔细取材寻找高分化脂肪肉瘤性成分,如果没有则需要加做 MDM2 的 FISH 检测首先除外去分化脂肪肉瘤可能。
参考文献:
Alaggio R et al: Undifferentiated high-grade pleomorphic sarcomas in children: a clinicopathologic study of 10 cases and review of literature. Pediatr Dev Pathol. 13(3):209-17, 2010
Chung L et al: Overlapping features between dedifferentiated liposarcoma and undifferentiated high-grade pleomorphic sarcoma. Am J Surg Pathol. 33(11):1594-600, 2009
